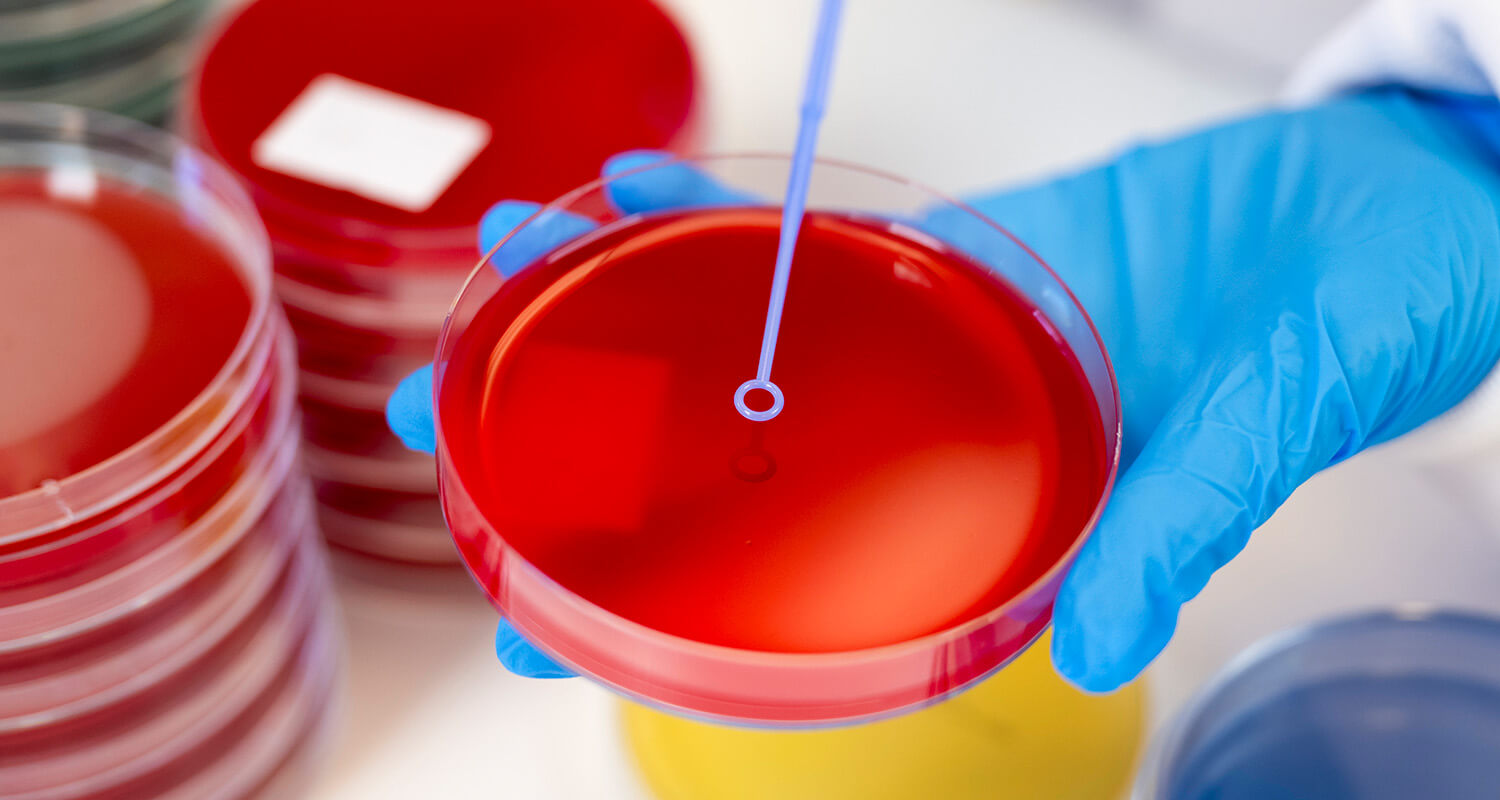
close-up of petri dish photo

HOSPITAL LABORATORY PHOTOGRAPHY
Client: Royal College of Pathologists
Photography commissioned by the Royal College of Pathologists to capture an extensive range of photographs of their professional members working in laboratories and teaching environments. These images are being used on their website, publications, and communications. The pathology locations across the North of England included; Leeds Teaching Hospitals NHS Trust, Liverpool University Hospital NHS Foundation Trust, Veterinary Pathology at the University of Liverpool, and Newcastle upon Tyne Hospitals NHS Foundation Trust.

LOCATION
Based in Leeds, Simon Vine Photographer is geographically well placed to provide professional architectural photography across the North of England, Yorkshire and Humberside. Including the cities of Leeds, Bradford, Wakefield, York, Sheffield, Doncaster, Hull, Manchester and Liverpool. Also Simon regularly travels around the UK on projects, working as required, day or night.
PROFILE
Experienced 20 Years+
Full Public Liability Insurance
DBS Checked
Full PPE Carried
RAMS Provided
Health & Safety always followed
